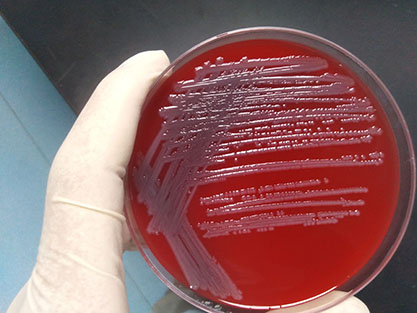

大肠杆菌
Escherichia coli
- BNCC358245
- BNCC
- 北京市
- 现货
- 按需
- 议价
- 2023-10-24 16:53:46
北京北纳创联生物技术研究院
一键申请试用
咨询
加入意向单
联系方式
- 英文名称
- Escherichia coli
大肠杆菌基本信息
| 培养基 | 胰蛋白胨:15.0,大豆胨:5.0,氯化钠:5.0,无菌脱纤维羊血:5%,琼脂:15.0,pH:7.3±0.2(25℃) |
| 传代方法 | ①准备1支含有5~10mL液体培养基的试管和2个平板;②安全柜中打开,用酒精灯灼烧顶部,后迅速滴上无菌水使之破裂,随后用镊子将其敲碎;③吸取0.5mL液体培养基打入冻干管,充分溶解后重新打回液体试管中,混匀;④吸取0.2mL菌悬液打入平板中,涂布均匀,重复两次获得两个平板;⑤将液体试管和平板全部置于上述培养条件下培养,菌种长出即可使用。 |
| 生长条件 | 30°C;18-24h;好氧; |
| 存储条件 | 2-8℃ |
| 安全等级 | 2 |
| 形态 | 大小:1-2mm 形状:圆形 边缘:整齐 透明度:不透明_x005f_x000D_ 颜色:灰白色 隆起度:中间凸起 表面:明亮光滑 质地:湿润易挑起 |
| 分离基物 | Human clinical isolate |
| 模式菌株 | 未知 |
| 应用领域 | AmpC cmy-2(寄存人)_x005f_x000D_ _x005f_x000D_ _x005f_x000D_ _x005f_x000D_ _x005f_x000D_ _x005f_x000D_ _x005f_x000D_ _x005f_x000D_ _x005f_x000D_ _x005f_x000D_ _x005f_x000D_ _x005f_x000D_ _x005f_x000D_ _x005f_x000D_ _x005f_x000D_ _x005f_x000D_ |
| 共享方式 | 公益性共享 |
为你推荐